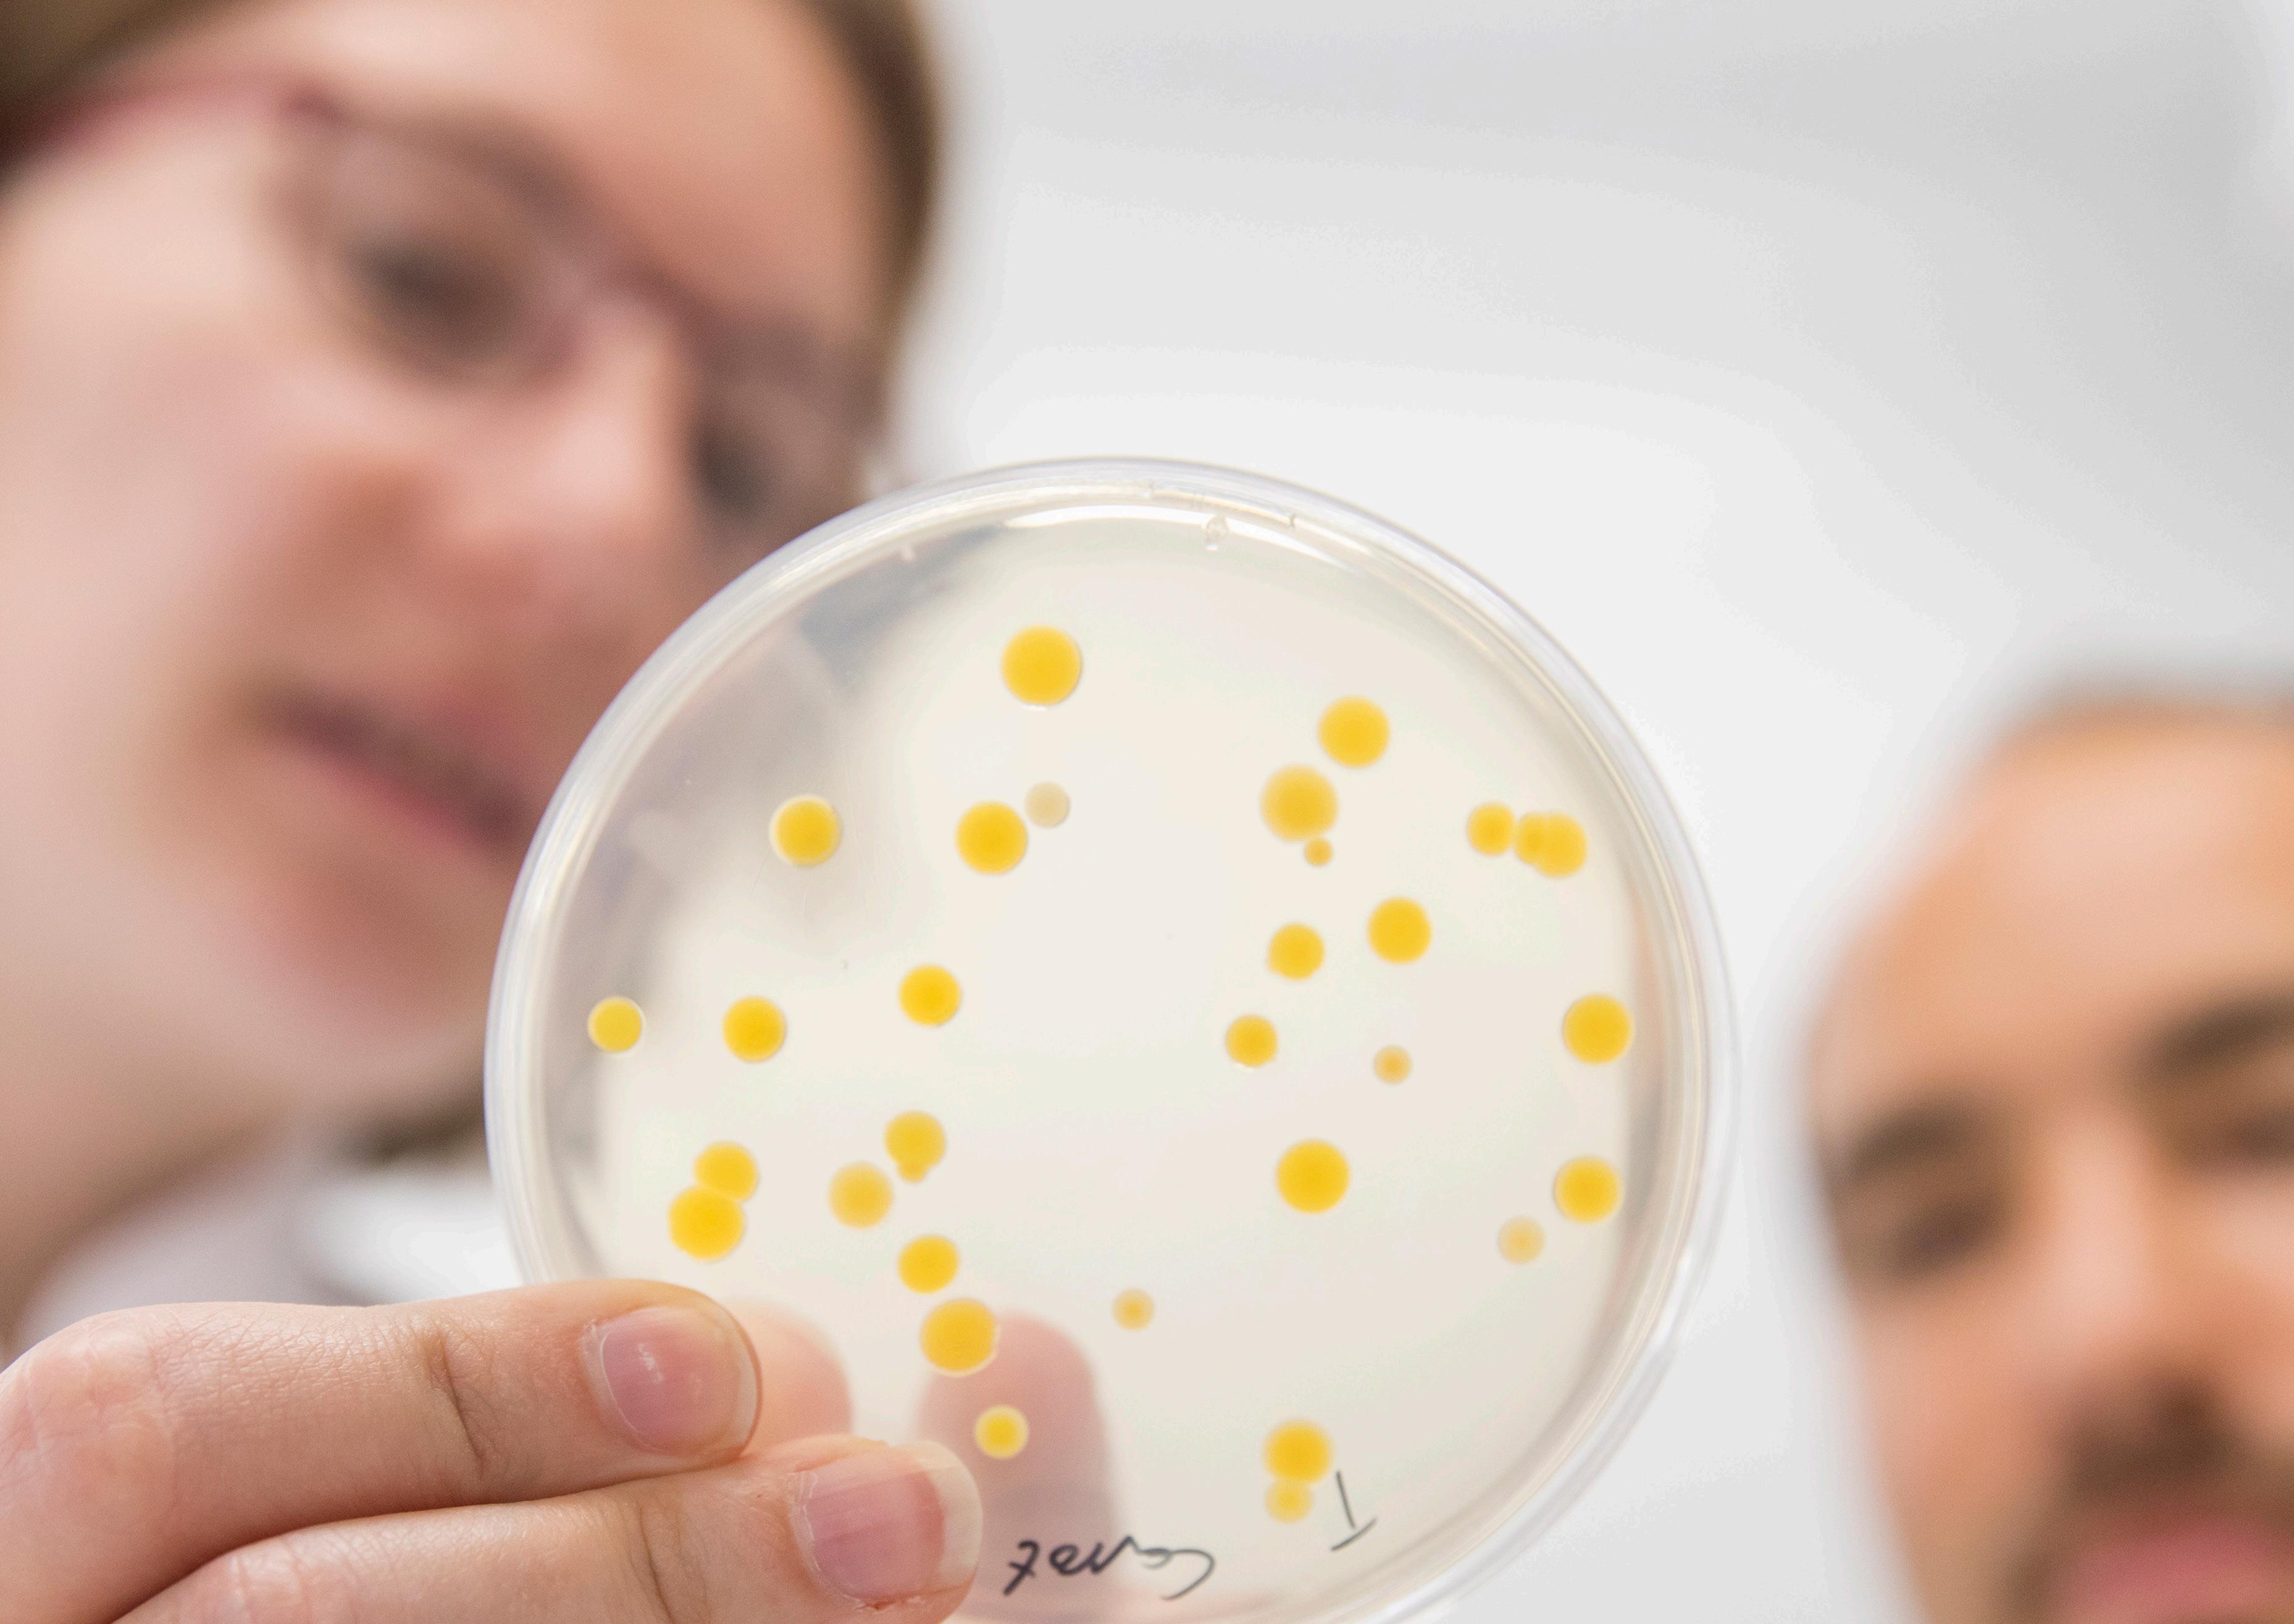

NAVIGATING THE FUTURE OF INNOVATIVE INGREDIENTS: TRENDS SHAPING THE NEXT 25 YEARS


![]()

NAVIGATING THE FUTURE OF INNOVATIVE INGREDIENTS: TRENDS SHAPING THE NEXT 25 YEARS


Croda’s 100-year milestone is a time to celebrate what we have achieved over the past century. And throughout 2025 we will be looking back to remind ourselves how far we have come and the impact we have had. But Croda’s growth and success during this past century has been grounded in its ability to look forwards – to recognise the emerging trends that are shaping its core markets, and to think innovatively about how to embrace them. So, during this centenary year it is as important to take stock of where we are and where we are going, as it is to recognise where we came from.
The next 25 years will see significant shifts in consumer care, pharmaceuticals, and agriculture – the main markets Croda serves. Driven by the rise of artificial intelligence, the demand for sustainability, and advances in biologics and biotechnology, the speciality ingredients industry is undergoing a transformation that will fundamentally alter how we develop, manufacture and supply innovative ingredients. We are clear about our role in that transformation. We recognise it will require us to embrace innovation and collaboration more than ever before, and adapt our thinking, cultures and approaches.
Based on views from Heads of R&D and Strategy across our business, this report outlines some of the current trends across our industry that may influence the future of the ingredients we and others develop and produce. It will then delve deeper into three markets to shine a light down the avenues that present the greatest opportunities for continuing to improve lives through smart science for the next 100 years.
Our outstanding people will continue to drive the positive impact we have on the planet and society. The successes of the past, the progress being made in the present, and our potential for the future all stem from the incredible intellect, passion and dedication of individuals who have made this company what it is today and who will determine its future. Without this cadre of exceptional people, this century of achievement would have been impossible. And those currently on the journey with us today are the driving force behind our continued push for innovation and excellence, inspiring us to reach new heights in the years to come.
Steve Foots, Group Chief Executive Officer


The 2024 World Economic Forum Global Risk Report demonstrates why environmental sustainability has already become a crucial agenda for our industry. The top four risks within a 10-year timeframe are all environment-related – natural resource shortages; biodiversity loss; critical changes to earth systems; and extreme weather events due to climate change. The social impacts of these are also called out, with involuntary migration and societal polarisation often the consequences of the climate and nature crises.
The perceived effect of these risks is now influencing individual product purchases. We can already see, for example, that a significant proportion of consumers want to buy more sustainable products from companies that are behaving responsibly and are providing solutions to climate change. That will continue to increase and the influence of sustainability on corporate decisions is therefore expected to grow, shaping the speciality ingredients sector more profoundly in the coming decades.
The key challenge for all companies in our industry is how to deliver net zero and combat deforestation across complex supply chains by transitioning to a nature positive ready portfolio. That cannot only be set as a corporate-level goal. It needs to filter down to individual products, where detailed data about how they perform today, what needs to change in the future and what progress is being made will be an essential part of tracking change. This is why our industry is looking closely at adopting lifecycle analysis (LCA) as a standard decision-making tool. This is a significant change – unlike current

measures for sustainability claims, LCA looks at the environmental impact of a product from ‘cradle to grave’ and involves a far more thorough analytical review of everything from development to sourcing and disposal. It means claims of sustainability will move beyond only reducing emissions, to a more rounded assessment of the entire value chain, where questions about carbon sources, biodegradability, and product end-of-life will be front of mind.
The shift from virgin petrochemical feedstocks to bio-based, recycled and waste materials will also gain momentum, with the proportion of virgin petrochemicals used in the ingredients industry expected to decline significantly over the next 25 years. However, as populations grow and the competition between biomass for food and these ingredients intensifies, bio-based materials that are perceived to be competing with food will come under increased scrutiny. Carbon is the building block upon which our industry is built and the challenge will be to find truly sustainable carbon sources as alternatives to both virgin petrochemicals and prime crop-based biomass. Various new carbon sources are being explored such as waste gas capture technologies as well as plant derived lignin as raw materials.
Across all these trends the implication is clear: sustainability is increasingly disrupting our industry. Companies in our sector will need to be able to work up and down their value chain to transform their methods and their portfolios so that they can deliver the net zero, nature positive solutions that customers and their consumers need.
Global supply chains for the ingredients we produce have been subject to immense pressure in recent years, and the next quarter-century will bring further change. Governments are increasingly focused on securing domestic production of these products, with the USA leading the charge by incentivising onshore manufacturing of critical ingredients under the banner of national security. In the face of geopolitical uncertainty, this localisation of supply chains is likely to spread to other countries, reversing globalisation that has been the pre-eminent force for many decades. Companies like Croda will need to expand their local footprint across sales, R&D, distribution and production. At the same time, distributed manufacturing – where companies set up smaller, mobile manufacturing units that can be relocated based on demand – will gain further prominence.
Biotechnology is already disrupting traditional ingredient manufacturing processes. That is expected to continue over the next 25 years as we see increasing emphasis on biotech solutions, particularly in pharmaceuticals and consumer care. There are three areas which hold considerable potential – plant cell cultures, fermentation and marine biotechnology:
As a world leader in plant cell cultures we understand the integral part this approach will play in the next 25 years of ingredient innovation. They offer the ability to protect biodiversity and natural ecosystems whilst simultaneously boosting innovation by enabling the production of specific compounds at very high levels of purity for advanced applications.
This represents a largely sustainable way to produce speciality ingredients using renewable biologically-derived resources. It reduces dependence on petrochemicals and supports the circular economy by using biological feedstocks and even waste materials.
With more than 80% of marine organisms still unexplored, the opportunity to discover novel compounds that could revolutionise product development across multiple industries is vast. Marine micro-organisms, such as those living in extreme environments like volcanic vents, could offer unique compounds with applications ranging from anti-ageing skincare products to new antibiotics.
Companies that invest in these approaches will have the opportunity to underpin the development of entirely new classes of ingredients where biotechnology provides the foundation for new drugs, personal care products, and even agricultural solutions. This not only opens up new revenue streams but also supports the industry’s move toward more sustainable and biologically-derived materials.
The growing reliance on biotechnology for active ingredients will continue to increase demand for bioprocessing aids to optimise production efficiency and scalability. As biotechnological processes involve complex biological systems like cell cultures or fermentation, bioprocessing aids, such as enzymes, stabilisers, and nutrient supplements, help ensure consistent yields, enhance process control, and reduce waste.
Personalisation will be one of the most exciting developments in both pharmaceuticals and consumer care during the next quarter of a century. In the realm of medicine, biologics are central to this change, transforming medicine through their ability to treat diseases in a much more targeted way than conventional approaches. This is not theoretical – cell and gene therapies are already being designed for individual patients with considerable success rates. As this trend continues, we can expect a future where drugs are no longer onesize-fits-all but tailored to the genetic makeup of each patient.
This trend will also feature in the consumer care market. Imagine walking into a store and having a formulation designed to uniquely suit your skin’s needs. This concept, while niche today, could become more commonplace in the next few decades, particularly in developed markets.
The implications for the speciality ingredients industry are immense, as an era of personalisation will require the development of a wider range of individual products and formulations to cater to the diverse needs of genetically unique consumers. Agility and the ability to scale up and down are both going to be essential qualities if our industry is going to meet the breadth of demand we can expect by 2050.
The most effective sources of innovation are collaborative efforts where knowledge sharing breeds novel thinking. This will not change in the next 25 years. We expect to see a particular rise in the role of university spin outs which are emerging at a rapid pace already, especially in the fields of biotechnology and AI-driven businesses. Large ingredients companies will need to collaborate closely with these emerging players. This could take the form of joint ventures, co-investment in new technologies, or even sharing manufacturing facilities to help smaller firms scale up their operations.
Our industry will also see even tighter partnerships with customers and suppliers.

Rather than developing products in isolation, companies will work alongside customers and suppliers to create solutions that meet specific needs, particularly in areas like sustainability and personalised medicine.
This will require a different type of partnership in which sharing data is an accepted norm and barriers between organisations throughout the supply chain become less cumbersome. That is going to require a level of cultural change within an industry that has historically taken a more protective and siloed approach.
AI is becoming an established tool in the speciality ingredients industry. It accelerates the discovery of new materials; improves production efficiency; enhances demand forecasting; and helps identify risks more accurately. There is still much more to come. The limits to AI’s potential in this environment come from the quality of data not simply the power of the tools. Whilst better tools will make it easier to process larger and more complex data sets; better data will improve the results of that work. As greater collaboration drives more parts of the value chain closer together, richer insight from shared data sets will be the outcome and it will fuel a leap in the impact of AI on all aspects of our sector.

DR. ANDY BUTTERWORTH
, VICE PRESIDENT - RESEARCH AND DEVELOPMENT, CRODA CONSUMER CARE
Almost 30 years’ experience of executional and strategic innovation delivery within the consumer care Industry.

The consumer care market can often be more susceptible to macro-level changes than either agriculture or pharmaceuticals. It operates in a faster-moving environment; it is more directly influenced by rapid shifts in consumer preferences; and its products are often trenddriven and therefore have shorter lifecycles demanding frequent innovation.
The result is a sector that relies on partners across the value chain that truly understand the trends shaping consumer decisions – both in the short term and further into the future – and can support consumer care companies to quickly adapt to those shifts. This is why those speciality ingredient companies that can track these trends and understand how to respond to them quickly and accurately are most likely to add significant value to their consumer care customers.
Here we outline four trends that we believe will have the most impact on the ingredient needs of consumer care companies by 2050.
The fallout from the COVID-19 pandemic, multiple regional wars, and instability in financial markets, has created an environment of global turbulence and a level of unpredictability that is not expected to be short-lived. This means economic markets can be subject to rapid and significant fluctuations, witnessed recently with a period of significant inflation.
Whilst higher interest rates may increase the disposable incomes of asset-rich consumers, the trickle-down effect of higher inflation is felt in the pockets of poorer consumers. People with less disposable income have hard choices to make about how they spend their money, with a knock-on effect on consumer care markets.
One phenomenon, noted amongst others by Leonard Lauder, chairman of Estee Lauder, in the wake of the 9/11 terrorist attacks, is that consumers with less disposable income still spend money on small indulges such as lipstick.
This so-called “lipstick effect” explains why consumers still tend to buy small luxury items to treat themselves even when they personally have little cash. By contrast, other consumers move to lower priced consumer goods, buying “value” products that will give them the required outcome at the lowest price.

For consumer care companies, maintaining market share in this environment means finding ways to create products that offer high performance at lower prices, representing better overall value than cheaper alternatives. To do this they often turn to their supply chain and seek support from ingredient companies in the form of more cost-effective products that do not compromise performance. So whilst these companies need to invest in process innovation to make higher-end ingredients cheaper to produce in the short term, they must balance this with a continuous need for product innovation to create brand new ingredients and materials that are even more advanced than those available today.
Economic growth in the developing world is outstripping established markets with Asia, the Middle East and Africa representing particular significant sources of future growth driven by an expanding middle class and urbansiation. This is leading to increased penetration of consumer care products across all cultures of the world, requiring ingredient suppliers to consider cultural and ethnic differences for their product portfolios. It also provides an opportunity for suppliers to help customers understand the performance benefits these emerging consumers are looking for and how they can market their products to them effectively.
An ageing population is also driving consumption, with the number of people over the age of 60 set to reach 22% by 2050 according to the World Health Organization, up from just 12% in 2015. Older people in developed markets tend to
have more disposable income and fewer responsibilities so they are more likely to make luxury or impulse purchases. And because people are living longer, as they get older they will also prefer products that make them feel healthier or look younger. Beauty is becoming synonymous with wellbeing, confidence and self-esteem at every stage in life, providing an opportunity to deliver improved outcomes for older people who are becoming a higher proportion of the global population.
The challenge for the ingredients industry over the next 25 years is therefore one of careful equilibrium to support the diverse consumers its customers need to satisfy.

Our environment is in distress and will continue to deteriorate for the next 25 years without transformational global change.
Yet the 2030 decarbonisation net zero targets to which governments around the world subscribed in the late 2010s and early 2020s are predicted to be missed by most. As a result, national governments are expected to pass the pressure down to corporations who will be required to step up and provide solutions. This is likely to come in the form of industry targets and regulation – such as those already in place in the automotive sector for electric and hybrid vehicles – and through extra taxation on products that undermine a country’s ability to meet national environmental commitments –such as the levy on plastic bags in UK shops.
We can expect that by 2050 these measures will have moved from packaging for consumer products to the raw materials from which they are made. Legislation and regulation in this area could become far more complex and give speciality ingredients companies more work to do to ensure compliance and remain competitive. Yet it also offers a significant opportunity for those companies with sustainability already at the centre of their strategy. Businesses that are seeking sustainable ways to increase the purity, performance, and provenance of their products, and those with the expertise to evidence their environmental impact from cradle to grave are likely to navigate the instability most effectively.
Within the next 25 years we are expected to witness a profound evolution in human augmentation through technology, driven by advancements in biotechnology, AI, robotics, and nanotechnology. This integration of technology with people has the potential to enhance physical, cognitive, and sensory capabilities, fundamentally altering how humans interact with their environment and each other. This matters for consumer care companies because their products are inherently connected to these interactions and experiences.
By 2050 we expect the most important impact of this augmentation will be the growth of biometric data and its ability to enable ‘ultra-personalisation’. Consumers are likely to track their skin and hair health in the same way they are already tracking physical health statistics. With widespread use of wearable and implantable devices that monitor health and wellness metrics, such as heart rate, hydration, or skin condition, consumer care companies can develop ultra-personalised products. Skincare products can be tailored to an individual’s real-time skin pH, hydration levels, or UV exposure; functional foods and supplements can be personalised to genetic and microbiome data; and haircare products can be formulated based on scalp and hair health analysis from biosensors.
This evolution will have a ripple effect on the companies that develop ingredients
for consumer care products, further blurring the boundary between beauty and pharma. Demand will expand to even more innovative and complex ingredients. These include supplements for beauty, gene-based beauty where insights on genetics from the pharma industry will be used to improve health and wellness, biocompatible materials suitable for use in close proximity to augmented technologies such as implants and sensors, and smart materials that can adapt to environmental or physiological changes. Manufacturing processes will need to become more agile to enable rapid prototyping and testing to match the speed at which bespoke products need to be offered to consumers. And this will all need to be delivered through sustainable methods, using sustainable materials – a daunting prospect when producing such innovative ingredients and working with such advanced materials.
Consumer care companies will need to rethink their portfolios for augmented consumers, creating products that seamlessly integrate with technological enhancements while promoting health and sustainability. For chemical companies, this evolution presents a unique opportunity to drive innovation by providing the advanced ingredients needed to meet these new demands. By staying ahead of these trends, ingredients suppliers can position themselves as indispensable partners in shaping the future of augmented human care.


DR. FINN BAUER, VICE PRESIDENT - RESEARCH AND DEVELOPMENT, CRODA LIFE SCIENCES

Finn Bauer drives pharmaceutical innovation through data-led research, leveraging over 20 years’ of global leadership in R&D and business roles.
There are transformative changes on the horizon for the pharmaceutical industry that will reshape how ingredients suppliers support this dynamic sector. The goals of pharmaceutical companies are increasingly combining curing patients as well as treating the symptoms of disease, alongside a greater emphasis on sustainability.
Companies that provide essential inputs for drug formulation and synthesis, must now adapt to support their customers’ shifting focus. As the industry moves towards precision therapies and greener processes, the speciality ingredients industry is undergoing a transformation that will fundamentally change the types of products it supplies to this market, and how it innovates to create them.
In this section we outline four trends that will inform those changes over the next 25 years, and how they could shape the future of innovative ingredients in the pharmaceutical industry.
In pharmaceuticals, the 20th century was the era of the small molecule –relatively simple compounds made by chemical synthesis. The 21st century is the era of biologics, much larger molecules manufactured inside animal cells or micro-organisms. Biologic drugs closely mimic our body’s biology and are much better at treating disease in a targeted way with fewer side effects.
The ability for these biologics to target specific cells and tissues provides an opportunity to reduce negative impacts both on patients, through fewer side effects, and on the planet through lower overall dosage and therefore fewer resources.
However, biologics are complex molecules that are hard to make and difficult to keep stable. They are also difficult to administer and are normally injected because otherwise they would be destroyed by stomach acid when
swallowed. To work properly they need sophisticated delivery systems.
Innovative ingredient companies such as Croda will be essential to empowering the widespread success of biologics by 2050 because they develop and provide solutions for manufacturing and delivering these drugs. Very few drug formulations comprise the Active Pharmaceutical Ingredient (API) alone. Most also incorporate components and systems for delivering that API to the target site in the body, maintain its stability and improve its efficacy. Furthermore, speciality ingredients enable yield increases and purity optimisation in biotech manufacturing. Developing those innovative new products, doing so using sustainable sources, and scaling their production to support commercial rollouts, will be a significant factor in how successfully the pharmaceutical industry can adapt to the future era of biologics.

The next phase in the move to biologics is characterised by the rise of genetic medicines that harness the power of nucleic acids (best illustrated by the global roll out of mRNA vaccines for COVID-19). This is creating an incredible number of opportunities because nucleic acids teach the body to create its own medicine. This is a fundamental shift in the complexity of new drugs and in their value – both in terms of patient outcomes and commercial opportunities for pharmaceutical companies.
The roll out of nucleic acid-based therapies over the next 25 years is expected to drive significant demand for novel drug delivery systems, such as transfection agents for gene and
cell therapy. It will require ingredients companies in the supply chain to innovate if they are to accommodate changing demands. This includes the development of scalable, more cost-effective production methods; greater stability and shelf life for the therapies themselves; and ways to boost the range of cells or tissues that nucleic acids can target.
More safety research, more regulation, and more market education around nucleic acids is also expected in the next quarter of a century. This will increase market confidence in their use, making them more viable as the foundation of a longer-term therapeutic revolution that will form the basis of multiple treatments and cures by 2050.
Personalised medicine is vital for curing diseases instead of just managing symptoms. To achieve this, the pharmaceutical industry is moving away from a “one-sizefits-all” approach and developing treatments tailored to individual patients or specific cells and tissues. This shift promises more effective therapies with fewer side effects, improved patient outcomes, and more curative potential.
An increase in personalised medicine will impact the entire industry, from patients to drug developers and their supply chains. Currently, curative treatments often rely on complex and costly external (in vitro) procedures, such as CRISPR. The goal is
to transition to internal (in vivo) treatments, which would simplify processes, reducing both cost and waste.
For ingredient companies this transition will mean increased demand for more precise drug delivery systems to ensure treatments reach the right target and deliver the right outcome on the first try. This, along with advancements in pharmaceutical raw materials will support the development of breakthrough therapies that may one day cure conditions like cancer and genetic disorders, which currently require lifelong management. Novel ingredients will be a foundation of that leap forward.

An improvement in the scale and quality of data available to pharmaceutical companies underpins all three trends above because harnessing more comprehensive datasets, including genetic, behavioural, and environmental data, can improve the performance of both drugs and delivery systems. The availability of much richer data will also allow for more precise dosing, meaning that companies can tailor dosages to fit each patient’s unique biology rather than prescribing the same drug dosage to everyone.
The ability of pharmaceutical companies to process and manage this scale of data is improving rapidly, thanks to innovations in AI and machine learning. However, the quality, structure, and accessibility of the data itself is proving to be a significant hurdle.
Much of the available data is fragmented, residing in different formats, across various platforms, and within siloed systems. This lack of uniformity hinders the creation of cohesive, predictive models. There is also an imbalance in the types of data available. While companies can easily collect and share positive data from successful drug formulations and clinical trials, there is a significant lack of negative data, information about

failures, non-effective treatments, or adverse outcomes. This is a critical gap because training machine learning algorithms to make accurate predictions requires exposure to both successes and failures. Without access to negative data, AI models are limited in their ability to innovate and push the boundaries of what’s possible. As pharmaceutical companies begin to aggregate and integrate their historical data, including both positive and negative results, AI systems will become far more effective at generating insights and predicting new therapeutic pathways.
This is where ingredients companies will play a vital role. Contributing data from ingredient innovation activities across the entire supply chain, from the processing of raw materials to the development of cutting-edge delivery systems, will enhance the insights the industry can draw. The ability to leverage all these comprehensive datasets will allow the entire sector to reduce the time and complexity associated with drug development – and therefore the cost for patients to access the resulting benefits. The challenge is how we can all become better at sharing, leveraging and exploiting data jointly, and in a more equitable way.

JAMES HUNT, GLOBAL STRATEGY DIRECTOR, CRODA AGRICULTURE
More than 20 years’ in the chemical industry across the agriculture and life sciences sectors, shaping market strategies and driving global businesses.

The agriculture industry is at a critical juncture. With a 70% increase in agricultural output required by 2050, the sector needs to deliver higher yields from less suitable land at the same time as restoring degraded ecosystems. As global demands for sustainability, food security, and environmental stewardship grow, the next 25 years will see chemical companies adapt to new technologies, methodologies, and philosophies to support this challenge.
Crop science companies and their ingredients suppliers, such as Croda, must evolve alongside these shifting dynamics to balance innovation in crop protection and enhancement with sustainability. We believe that there are four major trends that will shape the future of plant protection products to the agriculture sector over the next 25 years.
For decades, the agricultural industry has prioritised maximising crop yield and productivity above all else. This drive led to the development of high-yield crops, the intensive use of fertilisers, and significant advancements in pest management. But this focus on shortterm yield has come with long-term costs, bringing with it negative impacts on soil health, biodiversity, and increasing greenhouse gas emissions. As we look ahead, the imperative to restore nature while sustainably feeding a growing population is expected to intensify.
Crop science companies are now tasked with developing ingredients that not only
increase productivity but also improve soil regeneration and reduce environmental footprints. A combination of conventional and biopesticides, for example, represents a more precisely targeted and environmentallyfriendly alternative to traditional chemical pesticides alone. This trend reflects a broader movement in agriculture where novel inputs must contribute to both productivity and environmental sustainability, ensuring that future generations can continue to farm productively without further damaging the planet.

Historically, much of the agricultural industry’s focus has been on combatting biotic stresses, such as pests, weeds, and diseases, through synthetic pesticides and herbicides. While these innovations have significantly improved crop resilience, they often do little to address the abiotic stresses; such as drought, temperature extremes, and poor soil conditions, that can be just as damaging to crop yields.
Moving forward, a more balanced approach will be necessary, where both biotic and abiotic stresses are addressed simultaneously.
Genetic innovations, such as breeding crops to be more resilient to changing environmental conditions, will play a crucial role. Additionally, the rise of biostimulants – substances that enhance a plant’s resistance to abiotic stress – signals a new era for crop science suppliers. These products, which regulate plants’ biological responses to environmental stresses, allow crops to perform better under suboptimal conditions without relying heavily on synthetic chemicals. By addressing abiotic stresses more directly, suppliers such as Croda can help ensure stable crop yields in an increasingly unpredictable climate.
The past few decades have seen a gradual shift from traditional, synthetic chemical inputs towards biopesticides, particularly microbial-based products, and this trend is only set to accelerate. Microbial-based materials, which use beneficial microorganisms to promote plant health and resilience, offer several advantages over conventional chemicals. They are generally more environmentally friendly, reducing the carbon footprint associated with the manufacture and application of synthetic products. They can also improve soil health by promoting beneficial soil microbiomes, thus supporting long-term agricultural productivity.
The shift towards microbial products also helps address the growing problem of pest resistance. Many pests have developed resistance to synthetic pesticides, rendering them less effective over time. By introducing new microbial-based solutions, suppliers can offer innovative ways to combat pests while reducing the environmental impact of agriculture. This trend will likely expand as regulatory frameworks around the world place stricter limits on the use of synthetic inputs, encouraging the development of biological alternatives.
Data-driven agriculture has revolutionised the way farmers approach crop management. Historically, data has been used reactively, allowing farmers to identify areas within fields affected by pests, diseases, or poor soil conditions and then apply chemical inputs to address these issues. However, the next 25 years will see a shift towards using data as a predictive tool, largely driven by advances in artificial intelligence (AI).
The integration of AI and big data will allow farmers to anticipate problems before they occur, using predictive models that analyse weather patterns, soil conditions, and crop health. Suppliers across the crop value chain will need to adapt to this new paradigm by developing products that fit into these predictive frameworks. For instance, biostimulants could be applied in anticipation of a drought or pest
invasion, rather than as a response to it. This shift from reactive to proactive crop management will reduce waste, optimise the use of innovative crop science products, and help farmers achieve better results with fewer resources.
AI will also drive the adoption of precision agriculture technologies, such as drones and robotic systems, that can monitor fields in real-time and apply inputs only where needed. This precision not only reduces the environmental impact of novel crop inputs but also ensures that products are used as efficiently as possible. For crop science suppliers, this trend represents a significant opportunity to integrate their offerings into the digital agriculture ecosystem, positioning themselves as key players in the future of farming.


The many trends shaping the next 25 years for the speciality ingredients market – from sustainability and biotechnology to personalisation and even human augmentation – are all underpinned by three common themes: the necessity for innovation, agility, and collaboration.
Innovative ingredients are at the heart of how this industry will help its customers respond to these widespread changes. Novel research outcomes will not only enhance the performance of existing highquality products but also unveil new pathways to boost sustainability and streamline development and manufacturing processes, reducing time, waste, and costs.
Companies need to adapt to global changes quicker and become more agile. Faster research, analysis, and production processes driven by smarter thinking and the power of emerging technologies, particularly AI, will allow ingredient firms harnessing smart science to be more nimble and responsive. This will allow them to quickly adjust their commercial focus, their formulations, and the manufacturing processes that enable faster implementation.
Across all the themes in this report, the role of collaboration emerges as pivotal. Smart science companies developing novel ingredients are a big part of helping multiple sectors navigate the next quarter of a century. But they cannot do it alone. Whether through partnerships with biotech innovators, co-developing solutions with customers, or sharing data and resources, the future of the speciality ingredients industry will be shaped by its ability to work seamlessly across the value chain.
Every part of this ecosystem will feel the impact of the changes outlined in this report. By embracing them, companies in the ingredients industry can not only adapt but thrive, positioning themselves as indispensable partners in the innovations that will define the next quarter-century.




DR. ANDY BUTTERWORTH, VICE PRESIDENT - RESEARCH AND DEVELOPMENT, CRODA CONSUMER CARE

DR. FINN BAUER, VICE PRESIDENT - RESEARCH AND DEVELOPMENT, CRODA LIFE SCIENCES

DAMIAN KELLY, VICE PRESIDENT - INNOVATION & TECHNOLOGY DEVELOPMENT

JAMES HUNT, GLOBAL STRATEGY DIRECTOR, CRODA AGRICULTURE

PHIL RUXTON, CHIEF SUSTAINABILITY OFFICER
JENNIFER HART, VICE PRESIDENT - STRATEGY, CRODA CONSUMER CARE

HELEN JEREMIAH, GLOBAL VICE PRESIDENT -MARKETING, CRODA CONSUMER CARE
LAURA REILLY, GLOBAL VICE PRESIDENT - MARKETING, CRODA LIFE SCIENCES



croda.com
crodabeauty.com
crodahomecare.com
crodapharma.com
crodaagriculture.com